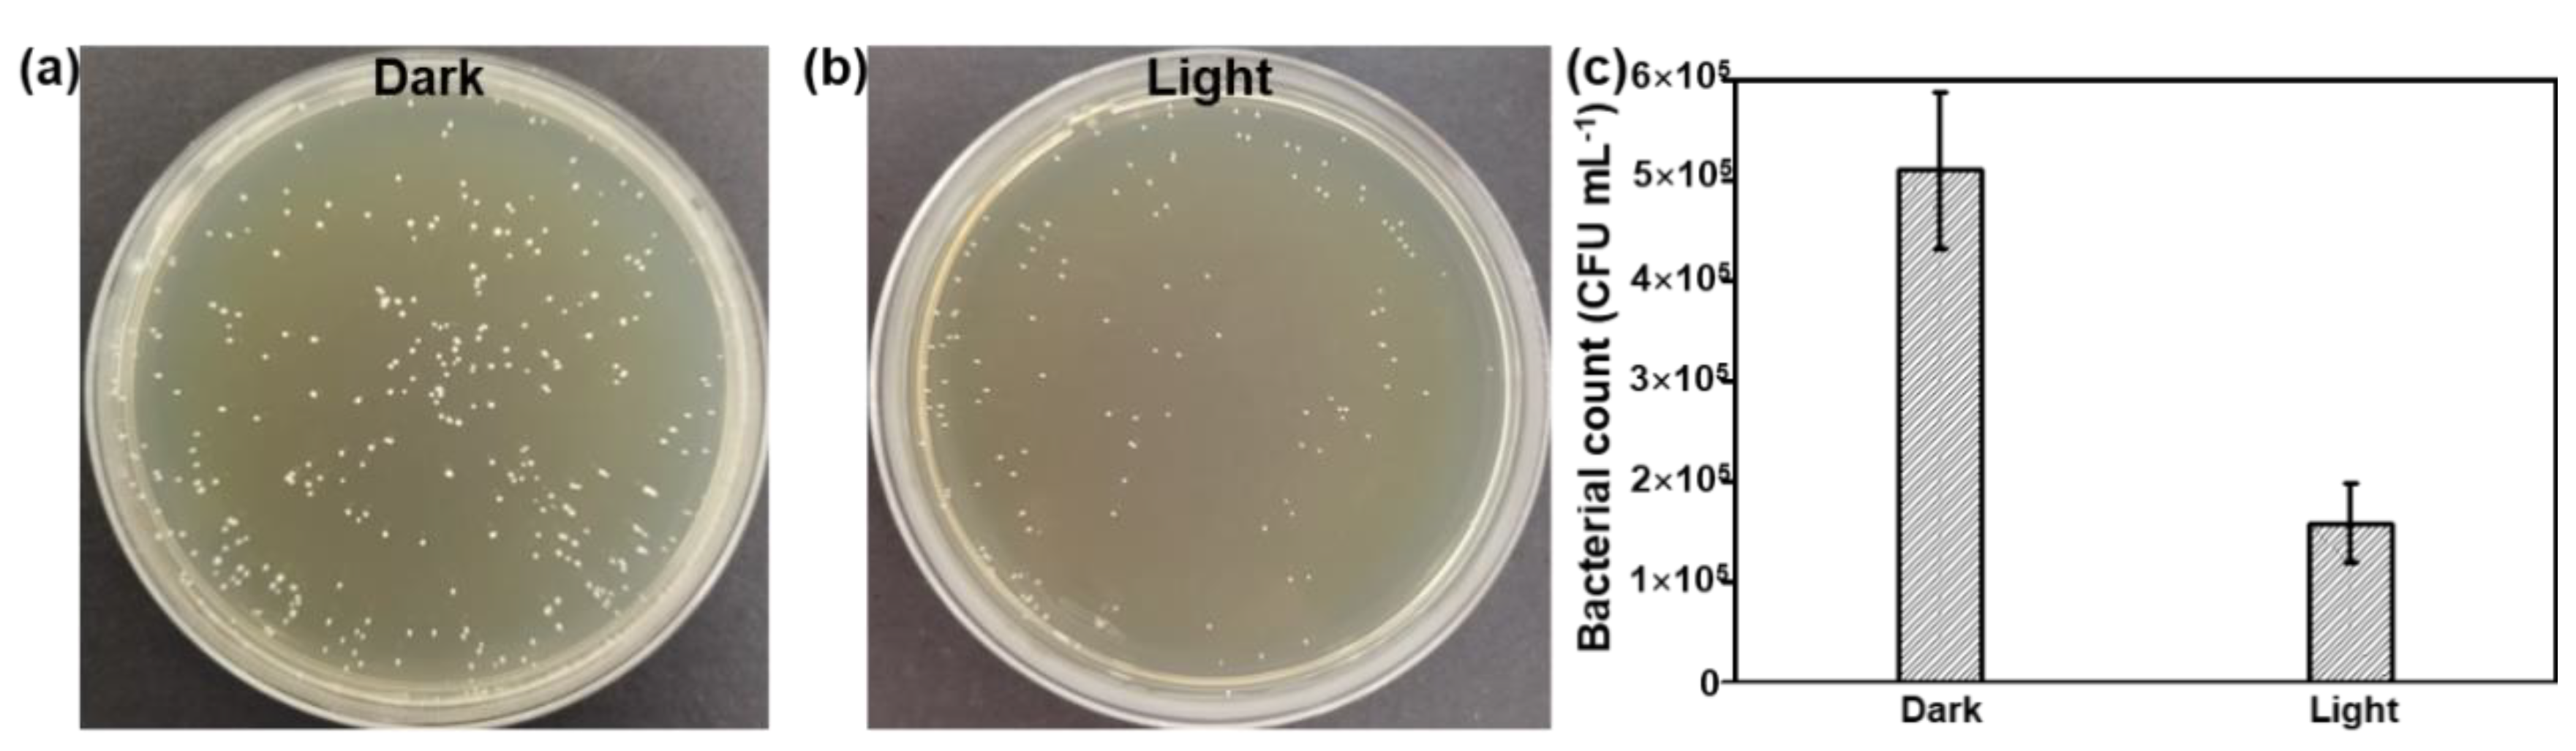
Nanomaterials 12 03911 g006 Nanomaterials 12 03911 g006

Bismuth Quantum Dot (Bi QD)/Polydimethylsiloxane (PDMS) Nanocomposites with Self-Cleaning and Antibacterial Activity for Dental Applications
Abstract
1. Introduction
2. Materials and Methods
2.1. Materials
2.2. Synthesis and Characterization of 0D Bi QDs
2.3. Preparation of Bi QD/PDMS-Modified Tooth
2.4. Hydrophobicity Evaluation
2.5. Antibacterial Activity Evaluation
2.6. Cytotoxicity Analysis
3. Results
4. Conclusions
Supplementary Materials
Author Contributions
Funding
Institutional Review Board Statement
Informed Consent Statement
Data Availability Statement
Conflicts of Interest
References
- Welch, K.; Cai, Y.; Engqvist, H.; Strømme, M. Dental Adhesives with Bioactive and On-Demand Bactericidal Properties. Dent. Mater. 2010, 26, 491–499. [Google Scholar] [CrossRef] [PubMed]
- Selwitz, R.H.; Ismail, A.I.; Pitts, N.B. Dental Caries. Lancet 2007, 369, 51–59. [Google Scholar] [CrossRef]
- Kim, S.; Park, C.; Cheon, K.-H.; Jung, H.-D.; Song, J.; Kim, H.-E.; Jang, T.-S. Antibacterial and Bioactive Properties of Stabilized Silver on Titanium with a Nanostructured Surface for Dental Applications. Appl. Surf. Sci. 2018, 451, 232–240. [Google Scholar] [CrossRef]
- Lee, S.J.; Heo, M.; Lee, D.; Han, S.; Moon, J.-H.; Lim, H.-N. Preparation and Characterization of Antibacterial Orthodontic Resin Containing Silver Nanoparticles. Appl. Surf. Sci. 2018, 432, 317–323. [Google Scholar] [CrossRef]
- Moussa, D.G.; Fok, A.; Aparicio, C. Hydrophobic and Antimicrobial Dentin: A Peptide-Based 2-Tier Protective System for Dental Resin Composite Restorations. Acta Biomater. 2019, 88, 251–265. [Google Scholar] [CrossRef]
- Fugolin, A.P.P.; Navarro, O.; Logan, M.G.; Huynh, V.; França, C.M.; Ferracane, J.L.; Pfeifer, C.S. Synthesis of Di- and Triacrylamides with Tertiary Amine Cores and Their Evaluation as Monomers in Dental Adhesive Interfaces. Acta Biomater. 2020, 115, 148–159. [Google Scholar] [CrossRef]
- Choi, W.; Park, S.; Kwon, J.-S.; Jang, E.-Y.; Kim, J.-Y.; Heo, J.; Hwang, Y.; Kim, B.-S.; Moon, J.-H.; Jung, S.; et al. Reverse Actuation of Polyelectrolyte Effect for In Vivo Antifouling. ACS Nano 2021, 15, 6811–6828. [Google Scholar] [CrossRef]
- Campos, K.P.L.; Viana, G.M.; Cabral, L.M.; Portela, M.B.; Hirata Junior, R.; Cavalcante, L.M.; Lourenço, E.J.V.; Telles, D.M. Self-Cured Resin Modified by Quaternary Ammonium Methacrylates and Chlorhexidine: Cytotoxicity, Antimicrobial, Physical, and Mechanical Properties. Dent. Mater. 2020, 36, 68–75. [Google Scholar] [CrossRef]
- Jandt, K.D.; Watts, D.C. Nanotechnology in Dentistry: Present and Future Perspectives on Dental Nanomaterials. Dent. Mater. 2020, 36, 1365–1378. [Google Scholar] [CrossRef]
- Park, S.; Jeong, H.-J.; Moon, J.-H.; Jang, E.-Y.; Jung, S.; Choi, M.; Choi, W.; Park, K.; Ahn, H.-W.; Hong, J. Polysilsesquioxane with Potent Resistance to Intraoral Stress: Functional Coating Material for the Advanced Dental Materials. Appl. Surf. Sci. 2022, 578, 152085. [Google Scholar] [CrossRef]
- Garcia, I.M.; Ferreira, C.J.; de Souza, V.S.; Leitune, V.C.B.; Samuel, S.M.W.; de Souza Balbinot, G.; da Motta, A.S.; Visioli, F.; Scholten, J.D.; Collares, F.M. Ionic Liquid as Antibacterial Agent for an Experimental Orthodontic Adhesive. Dent. Mater. 2019, 35, 1155–1165. [Google Scholar] [CrossRef] [PubMed]
- Blöcher, S.; Frankenberger, R.; Hellak, A.; Schauseil, M.; Roggendorf, M.J.; Korbmacher-Steiner, H.M. Effect on Enamel Shear Bond Strength of Adding Microsilver and Nanosilver Particles to the Primer of an Orthodontic Adhesive. BMC Oral Health 2015, 15, 42. [Google Scholar] [CrossRef]
- Blossey, R. Self-Cleaning Surfaces-Virtual Realities. Nat. Mater. 2003, 2, 301–306. [Google Scholar] [CrossRef] [PubMed]
- Dong, J.; Wang, D.; Peng, Y.; Zhang, C.; Lai, F.; He, G.; Ma, P.; Dong, W.; Huang, Y.; Parkin, I.P.; et al. Ultra-Stretchable and Superhydrophobic Textile-Based Bioelectrodes for Robust Self-Cleaning and Personal Health Monitoring. Nano Energy 2022, 97, 107160. [Google Scholar] [CrossRef]
- Wang, M.; Zhang, Z.; Wang, Y.; Zhao, X.; Yang, M.; Men, X.; Xue, Q. Colorful Superhydrophobic Pigments with Superior Anti-Fouling Performance and Environmental Durability. Chem. Eng. J. 2020, 384, 123292. [Google Scholar] [CrossRef]
- Tsuji, Y.; Yoshizawa, K. Competition between Hydrogen Bonding and Dispersion Force in Water Adsorption and Epoxy Adhesion to Boron Nitride: From the Flat to the Curved. Langmuir 2021, 37, 11351–11364. [Google Scholar] [CrossRef]
- Chiu, C.-Y.; Yen, T.-J.; Chang, Y. Intelligent Sterilizable Self-Cleaning Membranes Triggered by Sustainable Counterion-Induced Bacteria Killing/Releasing Procedure. Chem. Eng. J. 2022, 440, 135798. [Google Scholar] [CrossRef]
- Asha, A.B.; Peng, Y.-Y.; Cheng, Q.; Ishihara, K.; Liu, Y.; Narain, R. Dopamine Assisted Self-Cleaning, Antifouling, and Antibacterial Coating via Dynamic Covalent Interactions. ACS Appl. Mater. Interfaces 2022, 14, 9557–9569. [Google Scholar] [CrossRef] [PubMed]
- Wang, M.; Zhu, J.; Zi, Y.; Huang, W. 3D MXene Sponge: Facile Synthesis, Excellent Hydrophobicity, and High Photothermal Efficiency for Waste Oil Collection and Purification. ACS Appl. Mater. Interfaces 2021, 13, 47302–47312. [Google Scholar] [CrossRef]
- Wang, M.; Zi, Y.; Zhu, J.; Huang, W.; Zhang, Z.; Zhang, H. Construction of Super-Hydrophobic PDMS@MOF@Cu Mesh for Reduced Drag, Anti-Fouling and Self-Cleaning towards Marine Vehicle Applications. Chem. Eng. J. 2021, 417, 129265. [Google Scholar] [CrossRef]
- Anis, S.F.; Lalia, B.S.; Khair, M.; Hashaikeh, R.; Hilal, N. Electro-Ceramic Self-Cleaning Membranes for Biofouling Control and Prevention in Water Treatment. Chem. Eng. J. 2021, 415, 128395. [Google Scholar] [CrossRef]
- Wang, M.; Hu, Y.; Zi, Y.; Huang, W. Functionalized Hybridization of Bismuth Nanostructures for Highly Improved Nanophotonics. APL Mater. 2022, 10, 050901. [Google Scholar] [CrossRef]
- Wang, M.; Zhu, J.; Zi, Y.; Wu, Z.-G.; Hu, H.; Xie, Z.; Zhang, Y.; Hu, L.; Huang, W. Functional Two-Dimensional Black Phosphorus Nanostructures towards Next-Generation Devices. J. Mater. Chem. A 2021, 9, 12433–12473. [Google Scholar] [CrossRef]
- Huang, W.; Zhu, J.; Wang, M.; Hu, L.; Tang, Y.; Shu, Y.; Xie, Z.; Zhang, H. Emerging Mono-Elemental Bismuth Nanostructures: Controlled Synthesis and Their Versatile Applications. Adv. Funct. Mater. 2021, 31, 2007584. [Google Scholar] [CrossRef]
- Huang, W.; Wang, M.; Hu, L.; Wang, C.; Xie, Z.; Zhang, H. Recent Advances in Semiconducting Monoelemental Selenium Nanostructures for Device Applications. Adv. Funct. Mater. 2020, 30, 2003301. [Google Scholar] [CrossRef]
- Huang, W.; Hu, L.; Tang, Y.; Xie, Z.; Zhang, H. Recent Advances in Functional 2D MXene-Based Nanostructures for Next-Generation Devices. Adv. Funct. Mater. 2020, 30, 2005223. [Google Scholar] [CrossRef]
- Huang, W.; Zhang, Y.; You, Q.; Huang, P.; Wang, Y.; Huang, Z.N.; Ge, Y.; Wu, L.; Dong, Z.; Dai, X.; et al. Enhanced Photodetection Properties of Tellurium@Selenium Roll-to-Roll Nanotube Heterojunctions. Small 2019, 15, 1900902. [Google Scholar] [CrossRef]
- Huang, W.; Li, C.; Gao, L.; Zhang, Y.; Wang, Y.; Huang, Z.N.; Chen, T.; Hu, L.; Zhang, H. Emerging Black Phosphorus Analogue Nanomaterials for High-Performance Device Applications. J. Mater. Chem. C 2020, 8, 1172–1197. [Google Scholar] [CrossRef]
- Kakanakova-Georgieva, A.; Giannazzo, F.; Nicotra, G.; Cora, I.; Gueorguiev, G.K.; Persson, P.O.Å.; Pécz, B. Material Proposal for 2D Indium Oxide. Appl. Surf. Sci. 2021, 548, 149275. [Google Scholar] [CrossRef]
- Freitas, R.R.Q.; Brito Mota, F.; Rivelino, R.; Castilho, C.M.C.; Kakanakova-Georgieva, A.; Gueorguiev, G.K. Spin-Orbit-Induced Gap Modification in Buckled Honeycomb XBi and XBi3 (X = B, Al, Ga, and In) Sheets. J. Phys. Condens. Matter 2015, 27, 485306. [Google Scholar] [CrossRef]
- Li, D.; Huang, W.; Chu, H.; Li, Y.; Wang, Y.; Zhao, S.; Li, G.; Zhang, H.; Li, D. Passively Q-Switched Near Infrared Lasers with Bismuthene Quantum Dots as the Saturable Absorber. Opt. Laser Technol. 2020, 128, 106219. [Google Scholar]
- Pan, H.; Huang, W.; Chu, H.; Li, Y.; Zhao, S.; Li, G.; Zhang, H.; Li, D. Bismuthene Quantum Dots Based Optical Modulator for MIR Lasers at 2 μm. Opt. Mater. 2020, 102, 109830. [Google Scholar] [CrossRef]
- Xing, C.; Huang, W.; Xie, Z.; Zhao, J.; Ma, D.; Fan, T.; Liang, W.; Ge, Y.; Dong, B.; Li, J.; et al. Ultrasmall Bismuth Quantum Dots: Facile Liquid-Phase Exfoliation, Characterization, and Application in High-Performance UV-Vis Photodetector. ACS Photonics 2018, 5, 621–629. [Google Scholar] [CrossRef]
- Rostamifar, S.; Azad, A.; Bazrafkan, A.; Modaresi, F.; Atashpour, S.; Jahromi, Z.K. New Strategy of Reducing Biofilm Forming Bacteria in Oral Cavity by Bismuth Nanoparticles. Biomed. Res. Int. 2021, 2021, 6695692. [Google Scholar] [CrossRef] [PubMed]
- Li, W.; Fan, Y.; Lin, J.; Yu, P.; Wang, Z.; Ning, C. Near-Infrared Light-Activatable Bismuth-Based Nanomaterials for Antibacterial and Antitumor Treatment. Adv. Therap. 2022, 5, 2200027. [Google Scholar] [CrossRef]
- Cao, C.; Ge, W.; Yin, J.; Yang, D.; Wang, W.; Song, X.; Hu, Y.; Yin, J.; Dong, X. Mesoporous Silica Supported Silver-Bismuth Nanoparticles as Photothermal Agents for Skin Infection Synergistic Antibacterial Therapy. Small 2020, 16, 2000436. [Google Scholar] [CrossRef]
- Zheng, Y.; Dong, C.; Yang, J.; Jin, Y.; Zheng, W.; Zhou, Q.; Liang, Y.; Bao, L.; Feng, G.; Ji, J.; et al. Exosomal MicroRNA-155-5p from PDLSCs Regulated Th17/Treg Balance by Targeting Sirtuin-1 in Chronic Periodontitis. J. Cell Physiol. 2019, 234, 20662–20674. [Google Scholar] [CrossRef]
- Jiang, R.; Wang, M.; Shen, X.; Huang, S.; Han, J.; Li, L.; Xu, Z.; Jiang, C.; Zhou, Q.; Feng, X. SUMO1 Modification of IGF-1R Combining with SNAI2 Inhibited Osteogenic Differentiation of Pdlscs Stimulated by High Glucose. Stem Cell Res. Ther. 2021, 12, 543. [Google Scholar] [CrossRef]
- Cheng, L.; Weir, M.D.; Xu, H.H.K.; Antonucci, J.M.; Kraigsley, A.M.; Lin, N.J.; Lin-Gibson, S.; Zhou, X. Antibacterial Amorphous Calcium Phosphate Nanocomposites with a Quaternary Ammonium Dimethacrylate and Silver Nanoparticles. Dent. Mater. 2012, 28, 561–572. [Google Scholar] [CrossRef]
- He, Y.; Li, K.; Yang, X.; Leng, J.; Xu, K.; Yuan, Z.; Lin, C.; Tao, B.; Li, X.; Hu, J.; et al. Calcium Peroxide Nanoparticles-Embedded Coatings on Anti-Inflammatory TiO2 Nanotubes for Bacteria Elimination and Inflammatory Environment Amelioration. Small 2021, 17, 2102907. [Google Scholar] [CrossRef]
- Zhang, Y.; Huang, C.; Chang, J. Ca-Doped Mesoporous SiO2/Dental Resin Composites with Enhanced Mechanical Properties, Bioactivity and Antibacterial Properties. J. Mater. Chem. B 2018, 6, 477–486. [Google Scholar] [CrossRef] [PubMed]
- Lei, P.; An, R.; Zhang, P.; Yao, S.; Song, S.; Dong, L.; Xu, X.; Du, K.; Feng, J.; Zhang, H. Ultrafast Synthesis of Ultrasmall Poly(Vinylpyrrolidone)-Protected Bismuth Nanodots as a Multifunctional Theranostic Agent for In Vivo Dual-Modal CT/Photothermal-Imaging-Guided Photothermal Therapy. Adv. Funct. Mater. 2017, 27, 1702018. [Google Scholar] [CrossRef]
- Yang, Y.; Xu, Z.; Guo, Y.; Zhang, H.; Qiu, Y.; Li, J.; Ma, D.; Li, Z.; Zhen, P.; Liu, B.; et al. Novel Core-Shell CHX/ACP Nanoparticles Effectively Improve the Mechanical, Antibacterial and Remineralized Properties of the Dental Resin Composite. Dent. Mater. 2021, 37, 636–647. [Google Scholar] [CrossRef] [PubMed]
- Miki, S.; Kitagawa, H.; Kitagawa, R.; Kiba, W.; Hayashi, M.; Imazato, S. Antibacterial Activity of Resin Composites Containing Surface Pre-Reacted Glass-Ionomer (S-PRG) Filler. Dent. Mater. 2016, 32, 1095–1102. [Google Scholar] [CrossRef]
- Hojati, S.T.; Alaghemand, H.; Hamze, F.; Babaki, F.A.; Rajab-Nia, R.; Rezvani, M.B.; Kaviani, M.; Atai, M. Antibacterial, Physical snd Mechanical Properties of Flowable Resin Composites Containing Zinc Oxide Nanoparticles. Dent. Mater. 2013, 29, 495–505. [Google Scholar] [CrossRef]

Publisher’s Note: MDPI stays neutral with regard to jurisdictional claims in published maps and institutional affiliations. |
© 2022 by the authors. Licensee MDPI, Basel, Switzerland. This article is an open access article distributed under the terms and conditions of the Creative Commons Attribution (CC BY) license (https://creativecommons.org/licenses/by/4.0/).
Share and Cite
Hu, Y.; Xu, Z.; Hu, Y.; Hu, L.; Zi, Y.; Wang, M.; Feng, X.; Huang, W. Bismuth Quantum Dot (Bi QD)/Polydimethylsiloxane (PDMS) Nanocomposites with Self-Cleaning and Antibacterial Activity for Dental Applications. Nanomaterials 2022, 12, 3911. https://doi.org/10.3390/nano12213911
Hu Y, Xu Z, Hu Y, Hu L, Zi Y, Wang M, Feng X, Huang W. Bismuth Quantum Dot (Bi QD)/Polydimethylsiloxane (PDMS) Nanocomposites with Self-Cleaning and Antibacterial Activity for Dental Applications. Nanomaterials. 2022; 12(21):3911. https://doi.org/10.3390/nano12213911
Chicago/Turabian StyleHu, Yingzi, Zhiliang Xu, Yi Hu, Lanping Hu, You Zi, Mengke Wang, Xingmei Feng, and Weichun Huang. 2022. "Bismuth Quantum Dot (Bi QD)/Polydimethylsiloxane (PDMS) Nanocomposites with Self-Cleaning and Antibacterial Activity for Dental Applications" Nanomaterials 12, no. 21: 3911. https://doi.org/10.3390/nano12213911
APA StyleHu, Y., Xu, Z., Hu, Y., Hu, L., Zi, Y., Wang, M., Feng, X., & Huang, W. (2022). Bismuth Quantum Dot (Bi QD)/Polydimethylsiloxane (PDMS) Nanocomposites with Self-Cleaning and Antibacterial Activity for Dental Applications. Nanomaterials, 12(21), 3911. https://doi.org/10.3390/nano12213911

